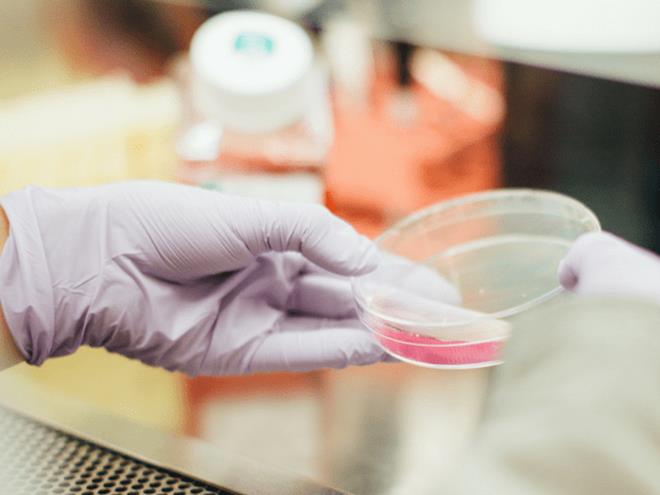
Uống quá nhiều cà phê, cơ thể thay đổi thế nào?-2

Tăng huyết áp: Nhiều nghiên cứu chứng minh rằng, cà phê có liên quan tới bệnh tim mạch và mức độ căng thẳng ở con người. Cụ thể, những người mắc bệnh tim thường được khuyến cáo không nên uống cà phê vì sẽ bị tăng huyết áp và dễ gặp biến chứng.
Không nhạy với insulin: Uống nhiều cà phê trong thời gian dài khiến cơ thể bạn không còn nhạy với insulin. Tình trạng này xảy ra khi các tế bào trong cơ thể không phản ứng với lượng đường trong máu. Đây chính là nguyên nhân gây ra bệnh suy giảm động mạch và các vấn đề về tim mạch.

Tăng nồng độ axit: Trong cà phê có một lượng axit nhất định nếu uống nhiều sẽ gây khó chịu về tiêu hóa, khó tiêu và nguy cơ phát triển bệnh tim mạch. Tình trạng này còn nghiêm trọng hơn đối với những người bị tiểu đường. Do vậy, bạn chỉ nên sử dụng cà phê ở lượng vừa phải để tránh nguy hại tới sức khỏe.

Gây nghiện: Hàm lượng caffeine trong cà phê sẽ tạo ra một số cảm giác tâm lý nhẹ nhõm. Tuy nhiên, nếu tiêu thụ quá nhiều cà phê sẽ khiến người dùng bị phụ thuốc, lâu ngày không dùng sẽ cảm thấy khó chịu.

Đi tiểu quá mức: Cà phê được biết đến là loại đồ uống lợi tiểu. Khi bạn đi tiểu quá mức, cơ thể sẽ đứng trước nguy cơ bị đào thải canxi, magie và các khoáng chất cần thiết khác gây thiếu hụt dinh dưỡng.

Cản trở quá trình giải độc của gan: Các thành phần trong cà phê gây cản trở quá trình chuyển hóa thuốc và giải độc của gan. Mặt khác, những người đang dùng thuốc điều trị tuyến giáp uống cà phê sẽ rất dễ gặp tác dụng phụ hoặc lượng thuốc hấp thụ vào cơ thể kém.

Mất ngủ, lo âu, trầm cảm: Caffeine trong cà phê sẽ làm trầm trọng hơn tình trạng lo lắng, trầm cảm thông qua việc kích thích não bộ. Vì vậy, bạn nên cân nhắc việc sử dụng cà phê sao cho ở ngưỡng hợp lý, tránh uống quá nhiều.

Táo bón: Cà phê khiến cho cơ thể giảm lượng nước nên gây ra tình trạng táo bón. Do đó, loại đồ uống này cũng được xếp vào danh sách thực phẩm người bị táo bón không được sử dụng.

Giảm khả năng sinh sản: Nghiên cứu cho thấy, cà phê có thể gây suy giảm khả năng sinh sản, đặc biệt là phụ nữ. Bởi đồ uống này có thể ngăn chặn sự phát triển của tế bào trứng.

Tăng nguy cơ sảy thai: Do chứa caffeien, cà phê được xếp đến là một chất gây kích thích và làm tăng nguy cơ sảy thai. Theo các chuyên gia, phụ nữ đang mang thai không nên uống quá 2 cốc cà phê mỗi ngày để tránh nguy cơ sinh non.
Theo VTC
